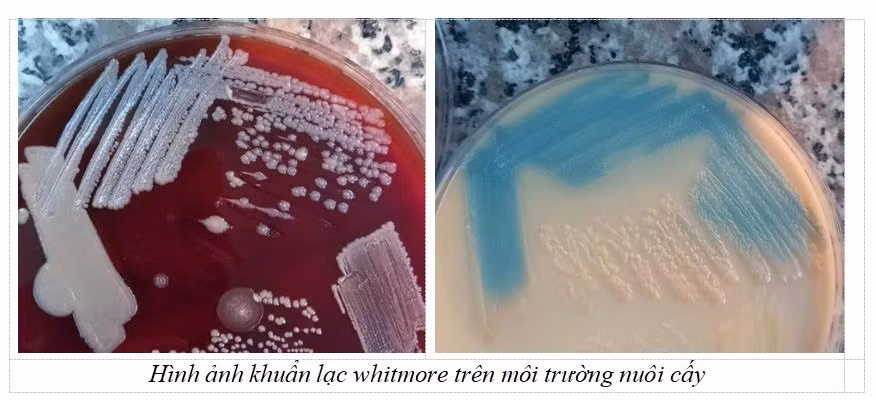
whitmore.jpg

Vi khuẩn đang lưu hành, gây bệnh trong cộng đồng
Burkholderia pseudomallei (hay còn gọi là vi khuẩn Whitmore, vi khuẩn ăn thịt người) là một trực khuẩn Gram âm tồn tại tự nhiên trong bùn đất và nước ở vùng khí hậu nhiệt đới, đặc biệt là ở tầng đất sâu.
Dòng nước lũ, ngập úng làm xáo trộn lớp đất mặt và tầng đất sâu, mang theo vi khuẩn B. pseudomallei phân tán ra môi trường rộng lớn, bao gồm cả nguồn nước sinh hoạt và khu vực dân cư.
Vi khuẩn xâm nhập vào cơ thể người qua vết trầy xước, vết thương hở khi người dân tiếp xúc trực tiếp với bùn, đất hoặc nước bẩn trong quá trình dọn dẹp sau lũ mà không sử dụng đồ bảo hộ.
Bệnh Whitmore là một bệnh nhiễm khuẩn cấp tính, bệnh rất khó phát hiện nhưng tiến triển rất nhanh. Tuyên Quang, với địa hình miền núi và trong một vài năm gần đây thường xuyên bị ngập lụt, đã tạo điều kiện lý tưởng cho vi khuẩn sinh sôi.
Dữ liệu tại Bệnh viện Đa khoa tỉnh Tuyên Quang cho thấy, trong thời gian vừa qua chúng tôi liên tiếp ghi nhận các ca bệnh được chẩn đoán dương tính với Burkholderia pseudomallei. Các ca bệnh xuất hiện rải rác tại nhiều khu vực bao gồm Yên Sơn, Chiêm Hóa và Sơn Dương, Hàm Yên, Minh Xuân… cho thấy vi khuẩn đã lưu hành và gây bệnh trong cộng đồng.
Sự gia tăng số ca mắc có mối liên hệ mật thiết với các đợt mưa lũ kéo dài. Điều này khẳng định lũ lụt đã tạo điều kiện lý tưởng cho vi khuẩn sinh sôi và phát tán rộng hơn trong môi trường đất và nước.
Burkholderia pseudomallei tồn tại tự nhiên trong tầng đất sâu. Dòng nước lũ, ngập úng đã cuốn trôi vi khuẩn lên bề mặt. Vi khuẩn xâm nhập vào cơ thể người chủ yếu qua vết trầy xước, vết thương hở trên da khi người dân tiếp xúc trực tiếp với bùn đất hoặc nước bẩn trong quá trình dọn dẹp sau lũ mà không dùng đồ bảo hộ.

Căn bệnh “giả dạng” tỷ lệ tử vong 40-60%.
Whitmore là một căn bệnh "giả dạng", dễ nhầm lẫn với lao, nhiễm khuẩn tụ cầu hoặc nhiễm khuẩn thông thường, dẫn đến chậm trễ trong điều trị và làm tăng tỷ lệ tử vong lên tới 40-60%.
Nhóm nguy cơ tử vong cao nhất là những người có bệnh nền mạn tính, vốn chiếm tỷ lệ lớn trong các ca bệnh đã được ghi nhận: Bệnh nhân Đái tháo đường (dễ bị nhiễm khuẩn huyết). Bệnh thận/gan/phổi mạn tính (Như suy thận mạn). Người nghiện rượu. Người có hệ miễn dịch suy giảm.

Bệnh Whitmore do vi khuẩn Burkholderia pseudomallei gây ra, có nhiều thể lâm sàng với các triệu chứng thường không đặc hiệu, dễ bị chẩn đoán nhầm.
Nhiễm khuẩn huyết (nặng nhất): Đây là thể bệnh nặng, nguy hiểm, thường có các biểu hiện: Sốt cao kéo dài không đáp ứng với các loại kháng sinh thông thường. Mệt mỏi toàn thân. Tiến triển nặng có thể dẫn đến sốc nhiễm khuẩn.
Viêm phổi: Thể này rất dễ bị chẩn đoán nhầm với lao phổi do các triệu chứng kéo dài, bao gồm: Ho kéo dài, đau ngực, khó thở, áp-xe đa cơ quan: Các ổ áp-xe (ổ mủ) có thể hình thành ở nhiều vị trí trong cơ thể, gây khó khăn cho chẩn đoán ban đầu (đặc biệt tại tuyến cơ sở) vì triệu chứng thường không rõ ràng. Nội tạng: xuất hiện các ổ áp-xe ở gan, lách, thận, tuyến tiền liệt. Ngoài da/mô mềm: Có thể có áp-xe dưới da hoặc ở vú.
Do triệu chứng lâm sàng đa dạng và không rõ ràng, chỉ có xét nghiệm vi sinh mới có thể khẳng định chính xác sự hiện diện của vi khuẩn Burkholderia pseudomallei trong cơ thể:
Cấy mẫu: Cấy máu hoặc cấy mủ từ các ổ áp-xe.
Kỹ thuật sinh học phân tử: Phản ứng chuỗi polymerase (PCR): Để phát hiện nhanh vật chất di truyền của vi khuẩn; Giải trình tự gen (Sequence): Để định týp vi khuẩn.
Bệnh Whitmore là một mối đe dọa sức khỏe cộng đồng cần được cảnh báo nghiêm túc sau các đợt mưa lũ, đặc biệt tại các khu vực thường xuyên bị ngập úng. Sự gia tăng các ca mắc được ghi nhận là lời khẳng định về mức độ lưu hành và phát tán của vi khuẩn Burkholderia pseudomallei trong môi trường.

Cách chủ động phòng chống bệnh Whitmore:
Đối với cộng đồng: Mọi người dân cần nâng cao ý thức tự bảo vệ bằng cách tuyệt đối mang đồ bảo hộ (ủng, găng tay) khi tiếp xúc với bùn đất, nước bẩn sau lũ.
Đối với Hệ thống Y tế: Cần nâng cao cảnh giác lâm sàng, ưu tiên chỉ định xét nghiệm Vi sinh (Cấy máu, cấy mủ) cho các ca sốt kéo dài, không đáp ứng kháng sinh thông thường, đặc biệt là ở nhóm nguy cơ cao.
Phát hiện sớm và điều trị tích cực bằng kháng sinh đặc hiệu, kéo dài (3-6 tháng) là chìa khóa để cứu sống người bệnh. Hãy cùng nhau chủ động phòng ngừa và hành động quyết liệt để đối phó hiệu quả với nguy cơ bùng phát bệnh Whitmore.
ThS.BS Phạm Thị Ánh Tuyết (Trưởng khoa Hóa sinh - Vi sinh, Bệnh viện Đa khoa tỉnh Tuyên Quang)































